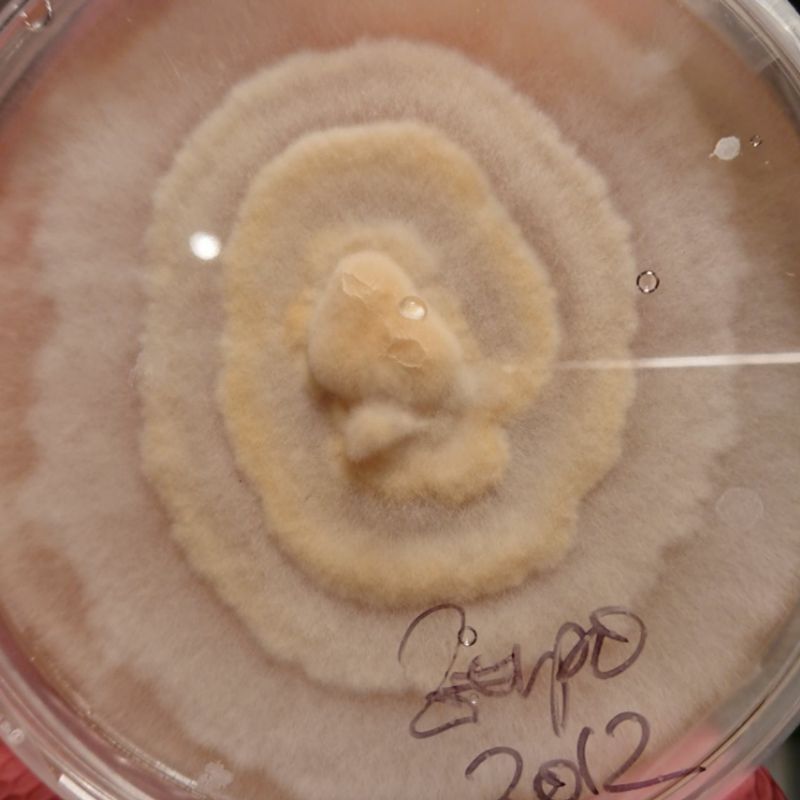
featured

Olli (57)
Mushroom Grower with passion and Love since 1995!
23 followers73 posts7 following1 HP
Blacklisted UsersMuted UsersFollowed BlacklistsFollowed Muted Lists
Blacklisted UsersMuted UsersFollowed BlacklistsFollowed Muted Lists
Shroomland youtube.com/user/Psilosemi/videos?view_as=subscriber Joined May 2020 Active 5 years ago